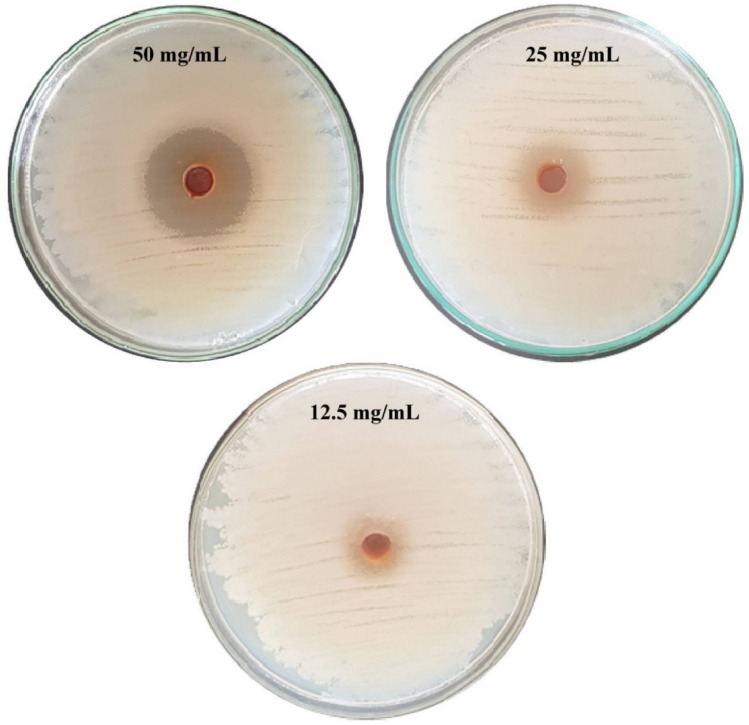

Abstract
Chitosan nanoparticles (CNPs) are promising versatile cationic polymeric nanoparticles, which have received growing interest over last few decades. The biocompatibility, biodegradability, environmental safety and non-toxicity of the chitosan nanoparticles makes it preferred for a wide range of biological applications including agriculture, medical and pharmaceutical fields. In this study, CNPs were biosynthesized by aqueous extract of Eucalyptus globulus Labill fresh leaves as bio-reductant. Box–Behnken design in 29 experimental runs was used for optimization of different factors affecting the production of CNPs. The maximum yield of CNPs was 9.91 mg/mL at pH of 4.5, chitosan concentration of 1%, incubation time of 60 min and temperature of 50 °C. The crystallinity, particle size and morphology of the biosynthesized CNPs were characterized. The CNPs possess a positively charged surface of 31.1 mV. The SEM images of the CNPs confirms the formation of spherical form with smooth surface. The TEM images show CNPs were spherical in shape and their size range was between 6.92 and 10.10 nm. X-ray diffraction indicates the high degree of CNPs crystallinity. FTIR analysis revealed various functional groups of organic compounds including NH, NH2, C–H, C−O, C–N, O–H, C–C, C–OH and C–O–C. The thermogravimetric analysis results revealed that CNPs are thermally stable. The antibacterial activity of CNPs was determined against pathogenic multidrug-resistant bacteria, Acinetobacter baumannii. The diameters of the inhibition zones were 12, 16 and 30 mm using the concentrations of 12.5, 25 and 50 mg/mL; respectively. When compared to previous studies, the biosynthesized CNPs produced using an aqueous extract of fresh Eucalyptus globulus Labill leaves have the smallest particle sizes (with a size range between 6.92 and 10.10 nm). Consequently, it is a promising candidate for a diverse range of medical applications and pharmaceutical industries.
Subject terms: Nanoparticles, Nanoparticles
Introduction
Chitosan is a biopolymer that consists of a straight chain and is a cationic polysaccharide. It is produced via the partial deacetylation of chitin. Chitosan has been used in the fabrication of nanoparticles. CNPs are materials with unique physicochemical characteristics, biocompatible, biodegradable, less toxic, easy to prepare and have a wide range of applications in medicine, agricultural and pharmaceutics. Due to their extremely small size, CNPs exhibit interesting interaction and surface characteristics. It is biocompatible and have been used in drug delivery, advanced cancer therapy and biological imaging and diagnosis1. It has been indicated by several studies that chitosan nanoparticles could be potential therapeutic agent for viral infections2. The extremely positive surface charge of CNPs makes stable nanoparticles that deliver drugs throughout the human body by a variety of mechanisms3. CNPs are applied for gene transfer in artificial organs as a controlled-release drug carrier and for immunological prophylaxis. It has been reported that CNPs could act as carriers for active substances that are utilized in hair and skin care products. CNPs were used to provide a prolonged release of hair growth agent, minoxidil sulphate, into hair follicles without dermal exposure4. Chitosan nanoparticles were also used as an additive in antimicrobial textiles for healthcare5. Chitosan nanoparticles were also used for herbicide delivery for weed eradication6, in insecticide7, nanofertilizer for balanced nutrition of plants8 and fungicide treatment9. Chitosan nanoparticles show effective antimicrobial activity against medical pathogens Escherichia coli, Klebsiella pneumoniae, Pseudomonas aeruginosa and Staphylococcus aureus10.
The different methods used for chitosan nanoparticles production include emulsification & crosslinking, precipitation-based methods, ionic gelation, ionic gelation with radical polymerization self-assembly, top–down approach, spray drying and supercritical-CO2-assisted solubilization and atomization11. The use of chemical and physical methods has many disadvantages which are the use of high-pressure, energy, temperature, toxic chemicals and the large particles size11–13. A self-assembled chitosan nanoparticles were prepared in the range 277–731 nm14. Nguyen et al.15 reported that the mean size of CNPs synthesized using tripolyphosphate (TPP) ionic gelation coupled with spray drying varied between 166 and 1230 nm depending on the chitosan molecular weight and the spray dryer needles diameter. Van et al.16 reported that the average size and size distribution of CNPs produced by nano spray dryer were from 300 to 3500 nm and the average size about 1000 nm depending on the size of the spray cap holes. According to the findings of Ha et al.8, the size distribution of the CNPs that were synthesized using ionic gelation of TPP and chitosan solution ranged from 300 to 750 nm. Ghormade et al.17 reported that the typical size range of nanoparticles that were used for nanoherbicides, nanopesticides and nanofertilizers in agricultural field was between 100 and 500 nm. As a result, there is a critical need to develop environmentally safe strategies for nanoparticles synthesis with ultrafine size.
Green approaches were utilized to produce ultrafine nanoparticles with a size of less than 100 nm, which is a crucial characteristic for a great number of applications in which the specific surface area plays a role18. Microorganisms such as bacteria19 and fungi20 were used for the biosynthesis of nanoparticles. Additionally, secondary metabolites found in plant leaves extracts were used as a reducing agent for nanoparticles biosynthesis21. It is claimed that biological agents act as stabilizers, reducers, or both during the nanoparticle formation process22. Eucalyptus (family, Myrtaceae) is one of the most widely planted genera on the world23. Besides essential oils the Eucalyptus genus contains; flavonoids (eucalyptin (5-hydroxy-7, 4'-dimethoxy-6, 8- dimethylflavone), triterpenes (ursolic acid), long chain ketones (tritriacontane-16, 18-dione and its 4-hydroxy equivalent), glycosides, acylphloroglucinol derivatives and a combination of many different chemical entities. The leaf waxes are an illustration of the variety of compounds found in Eucalyptus.
Antimicrobial drug resistance has progressively developed over the past several decades and is one of the most important challenges since many microbial infections are getting more resistant to currently marketed antimicrobial medications24–26. Due to the increasing incidence of pathogenic multidrug-resistant bacteria, the pharmaceutical industry has an urgent need for more rational approaches for the discovery of innovative medications27. Acinetobacter baumannii strains are a common pathogen that can cause severe nosocomial infections acquired in hospitals, particularly in intensive care units. These infections can include bacteremia, pneumonia, and urinary tract infections28, skin infections and soft-tissue in patients with burn injuries. Additionally, strains of Acinetobacter baumannii have the ability to create a biofilm, which is one of the major bacterial pathogens. This is due to the fact that biofilms are resistant to multiple classes of antibiotics including tetracyclines, carbapenems, aminoglycosides, fluoroquinolones, and other extended-spectrum β-lactams29,30. Consequently, it is vital to find novel strategies to avoid and treat infections caused by biofilm forming Acinetobacter baumannii strains.
Biosynthesis of chitosan nanoparticles is affected by various conditions such as temperature, pH, incubation time and chitosan concentration. The statistical design, including the response surface methodology, is efficient for optimization operational parameters. The response surface methodology (RSM) is a set of mathematical and statistical methods for building models, designing experiments, and finding the optimum conditions for optimizing the reaction conditions. There are several advantages for using RSM that includes suitability for multiple factors experiments, less experiment numbers, finding of the best suitable conditions and studying the interaction between the factors 31–33.
In the previous studies, the mean size of CNPs synthesized by ionic gelation, nano spray dryer and self-assembly varied between 166 and 3500 nm8,14–16. Bekmukhametova et al. 34 stated that, it is still challenging to produce a reliable protocol for the fabrication of chitosan nanoparticles in the 200–300 nm range. The chitosan nanoparticles with sizes ranging from 10 to 80 nm shown potential for nanomedicine, biomedical engineering, industrial, and pharmaceutical fields35. Therefore, there is a critical need to develop safe strategies for CNPs biosynthesis with ultrafine size for biomedical applications. In the present study, an extract of Eucalyptus globulus Labill leaves was used to produce ultrafine CNPs with a size range between 6.92 and 10.10 nm. This is a crucial characteristic for many applications where the specific surface area is important.
This study was mainly focused on the green synthesis of chitosan nanoparticles from chitosan solution by using Eucalyptus globulus Labill leaves extract. The characterizations of the biosynthesized nanoparticles were also performed and the antibacterial activity of the CNPs were evaluated against biofilm forming Acinetobacter baumannii as a test strain.
Materials and methods
Preparation of the plant extract
Fresh Eucalyptus globulus Labill leaves (Supplementary Fig. S1) were collected from Wadi El Natrun in northwest Egypt (30°21′1.08′′ E longitude and 30°22′39′′ N latitude) 23 m below sea level, and 38 m below the Nile River, Northern West Delta Egypt. Permission was obtained for collection of leaves. The plant was kindly identified by Prof. Dr. Mohamed Fathy Azzazy, head of Surveys of Natural Resources Department, Environmental Studies and Research Institute, University of Sadat City, Egypt. The voucher specimen (Eucalyptus globulus Labill) has been deposited at the herbarium of Environmental Studies and Research Institute, at University of Sadat City, Egypt. The Eucalyptus globulus Labill leaves were collected according to institutional, national, and international guidelines and legislation.
The plant leaves were rinsed three times with tap water, followed by a final washing with distilled water to remove any remaining dirt, then chopped into appropriate pieces. For the biosynthesis of chitosan, the Eucalyptus globulus Labill leaves extract was prepared by mixing 25 g of chopped leaves with one hundred milliliters of distilled water, boiling for ten minutes, and filtering through filter paper. This filtrate represented a 100% Eucalyptus globulus Labill leaves extract.
Biosynthesis of chitosan nanoparticles (CNPs)
Chitosan (with purity > 90% and viscosity 60–300 from BIO BASIC INC) got dissolved at 1 percent (w/v) with 1 percent (v/v) acetic acid. The pH was adjusted to 4.8 ± 0.02 with 1 N NaOH. To ensure that the chitosan was entirely dissolved in the solution, it was stirred for twenty-four hours. 10 mL of Eucalyptus globulus Labill leaves extract was added to 10 mL of the chitosan solution (1:1 v/v). CNPs were obtained by shaking the mixture at 110 rpm for 60 min at 50 °C. After incubation, the CNPs suspension was centrifuged at 10,000×g for ten minutes, then freeze dried. The UV/VIS absorbance spectrum of the biosynthesized CNPs was obtained using a double beam spectrophotometer and the highest absorption shown at the wavelength of 295 nm. The concentrations of CNPs (mg/mL) were determined quantitatively based on the standard curve of different concentrations of the lyophilized CNPs (over the concentration range of 1.5–15 mg/mL) with an R2 value of 0.9469.
Box–Behnken design optimization of biosynthesized CNPs
Box–Behnken experimental design36 is a response surface method that could be used to obtain maximum response and to observe the interactions among the process factors and the response. To obtain maximum biosynthesis of CNPs, the independent variables including initial pH (A), incubation time (B), chitosan concentration (C), and temperature (D) were coded in three levels (−1, 0, 1). 29 experimental runs using 24 factorial points and five replicates at the central point.
The following second-order polynomial equation is used to fit the RSM experimental results using the response surface regression approach:
| 1 |
are the coded levels of independent variables, and Y is the predicted response, is the interaction coefficient, is the linear coefficient, is the quadratic coefficient, and is the regression coefficient.
Statistical analysis
The Box–Behnken design was created by Design-Expert software (Version 7.0.0, Stat-Ease, Inc., Minneapolis, MN, USA). Multiple regression analysis was performed on the experimental data to determine the analysis of variance (ANOVA), to determine P˗value, F-value, and confidence levels. The coefficient of determination (R2) and adjusted R2. STATISTICA (Version 8, StatSoft, Inc., Tulsa, OK) software was applied to generate three-dimensional surface plots.
Characterization of chitosan nanoparticles
UV–visible spectrum
The biosynthesized chitosan nanoparticles were scanned to detect the absorbance peak using an Optizen Pop-UV/Vis spectrophotometer between the wavelengths of 200 and 400 nm.
Zeta potential of the synthesized chitosan nanoparticles
The zeta potential of the biosynthesized CNPs sample was determined at "Central Laboratories, City of Scientific Research and Technological Applications, Alexandria, Egypt" using a Malvern 3000 Zetasizer Nano ZS, UK”. The concentration of the biosynthesized CNPs suspension was reached to 0.01 weight percent by diluting it with deionized water. The diluted CNPs suspension was first homogenized in a high-speed homogenizer at a speed of 13,000 rpm for 10 min before the analysis, after which it was kept in an ultrasonic bath. The sample was analyzed thrice.
X-ray diffraction (XRD) pattern
XRD is one of the most essential tools for characterizing the structural features of CNPs. X-ray diffraction measurements were carried out at ambient temperature using a diffractometer type: Bruker D2 Phaser second Gen using a Ni-filtered Cu Kα radiation (λ = 1.54 A°). The generator was running at 10 kV with a current of 30 mA. Data were collected at a scanning rate of 2°/min for 2θ between 0 and 40.
Differential scanning calorimetry (DSC)
The thermal properties of CNPs were investigated using differential scanning calorimetric (DSC) analysis at the Central Laboratory, City of Scientific Research and Technological Applications, Alexandria, Egypt. Freeze-drying sample of approximately 3.2 mg was used. The sample was analyzed at a flow rate of 30 mL/min under nitrogen atmosphere. The temperatures used during the scan ranged between 25 to 300 °C.
Thermogravimetric analysis (TGA)
CNPs sample was analyzed using TGA-50H Thermogravimetric analyzer on a sample of approximately 6 mg. The sample was analyzed at a flow rate of 40 mL/min while being subjected to temperatures ranging from room temperature to 500 °C.
Fourier transform infrared (FTIR) measurements
The FTIR spectroscopy investigation has been carried out in order to investigate the surface characteristics of CNPs. For surface characteristics investigation, sample of CNPs was ground with KBr pellets. The Shimadzu FTIR-8400 S spectrophotometer was used to take the measurements for the CNPs' FTIR spectrum. The scanning range was between 500 and 4500 cm–1 with a 1 cm–1 resolution.
SEM and TEM investigations of CNPs samples
Scanning electron microscopy (SEM) investigation was used to detect the surface morphology, size and shape of CNPs. Sample of CNPs coated with gold by using a sputter coater (SPI-Module). The coated CNPs sample was investigated at the Electron Microscope Unit, Faculty of science, Alexandria University, Alexandria, Egypt with SEM “model JEOL-JSM-IT200; at 20 kV”. The CNPs morphology was also investigated by Transmission Electron Microscope (TEM) “JEM-2100 Plus, JEOL Ltd., Japan; at the Central Laboratory, City of Scientific Research and Technological Applications, Alexandria, Egypt”.
Energy dispersive X-ray Spectroscopy (EDX), which obtained using TEM, is often used for determining a sample's elemental composition.
Bacterial strain, growth conditions and antibacterial activity
Antibacterial activity was tested against multidrug-resistant Acinetobacter baumannii bacteria isolated from clinical specimens and kindly provided by Mabaret El Asafra Hospital, Alexandria, Egypt. Acinetobacter baumannii strain is resistant to ticarcillin/clavulanic acid, meropenem, cefepime, imipenem, ceftazidime, piperacillin, piperacillin/ tazobactan, ticarcillin, ciprofloxacin and minocycline. A. baumannii strain is susceptible to colistin and trimethoprim/sulphamethoxazole drug. A stock culture of A. baumannii was grown on nutrient agar medium then incubated at 30 °C for 24 h before being stored at 4 °C until use.
The well-diffusion method was used to test the ability of the biosynthesized CNPs to inhibit the growth of multidrug-resistant Acinetobacter baumannii bacteria using swab inoculation assay method. Bacterial suspension was prepared according to the method of Amini Tapouk et al.37. In sterilized Petri dishes, 50 mL of nutrient agar medium was poured and allowed to solidify. After solidifying, the nutrient agar plate surfaces were inoculated by spreading a volume of the bacterial suspension over the nutrient agar plate surface. Then, wells with a diameter of 6 mm were punched aseptically, and a volume of 100 µL of the CNPs were introduced into the well. Petri plates were incubated at 37 °C for 24 h. Following the incubation period, the plates were examined to determine whether or not inhibition zones had developed around the wells. The diameter of the inhibition zone surrounding the well, including the diameter of the well, was measured in millimeters.
Investigation of chitosan nanoparticles effect on A. baumannii cells
The bacterial cells were cultured in nutrient broth medium. After incubation time, the bacterial cells were harvested by centrifuging at 6000×g for 10 min and then suspended them in water. The bacterial cells suspended in water were treated with CNPs and incubated at 37 °C for an hour. The residues of treated cells were collected and fixed with formalin-glutaraldehyde fixative in 0.1 M phosphate buffer solution (pH 7.2) at 4 °C for 3 h prior to examination. After treatment, the cell residues were post-fixed in OsO4 (osmium tetroxide) at a concentration of 2% in the same buffer for 2 h at 4 °C.
The residues of treated cell were post-fixed in 2% osmium tetroxide (OsO4) in the same buffer for 2 h at 4 °C, washed with the buffer, and dehydrated in a graded series of acetones at 4 °C. The residues of treated cells were then embedded in a polymerizing resin before being sectioned to a thickness of 90 Angstroms. Sections should be stained with uranyl acetate for 5 min on the grid cobber, followed by 2 min of lead citrate staining38. Transmission electron microscopy (JEOL-JSM-1400 PLUS, Alexandria, Egypt) was used to investigate the effect of CNPs on the cell morphology of the multidrug resistant A. baumannii.
Results and discussion
Many different approaches have been utilized in the synthesis of chitosan nanoparticles. The stability and safety of the CNPs, in addition to the particle size, are factors that should be considered when choosing an acceptable preparation process39. In this study, E. citriodora leaves extract was used for CNPs biosynthesis. Figure 1A shows chitosan solution, leaves’ extract, and the biosynthesized chitosan nanoparticles. The biosynthesized CNPs were analyzed and characterized with the UV/VIS spectral range of 200–400 nm (Fig. 1B). The optical characteristics of CNPs revealed a single peak, and the highest absorbance was measured at a wavelength of 295 nm.
Figure 1.

(A) Three vials contain (1, Chitosan solution; 2, Eucalyptus globulus Labill leaves extract; 3, biosynthesized chitosan nanoparticles). (B) UV–vis spectrum of chitosan nanoparticles biosynthesised using Eucalyptus globulus Labill leaves extract.
Optimization of process parameters to maximize chitosan nanoparticles biosynthesis using Box–Behnken design (BBD)
In order to achieve optimal conditions for biosynthesis of chitosan nanoparticles, the Box-Behnken design (BBD) was used. As shown in Table 1, each variable was investigated at three distinct levels (−1, 0, and 1). A total of 29 runs were used to optimize the levels of the selected variables, with 5 runs (runs 15, 17, 21, 25, and 27) at the middle level (center point runs). As indicated in Table 1, the minimum production of CNPs was 3.69 mg/mL in run no. 6 at a pH of 4, an incubation time of 60 min, a chitosan concentration of 0.5%, and a temperature of 50 °C. On the other hand, the maximum production of CNPs was 9.91 mg/mL in run number 15 under the following conditions: pH: 4.5, incubation duration: 60 min, chitosan concentration: 1%, and temperature: 50 °C. Table 1 displays both the actual and predicted results of the biosynthesized CNPs. It can be demonstrated that the experimental results of the biosynthesized CNPs slightly differ from the predicted results.
Table 1.
Box–Behnken design matrix mean actual and predicted values of chitosan nanoparticles biosynthesis using Eucalyptus globulus Labill leaves extract.
| Std | Run | A | B | C | D | Chitosan nanoparticles (mg/mL) | ||
|---|---|---|---|---|---|---|---|---|
| Actual | Predicted | Residuals | ||||||
| 5 | 1 | 0 | 0 | −1 | −1 | 4.59 | 4.55 | 0.04 |
| 21 | 2 | 0 | −1 | 0 | −1 | 9.36 | 9.29 | 0.07 |
| 6 | 3 | 0 | 0 | 1 | −1 | 9.26 | 9.36 | −0.10 |
| 15 | 4 | 0 | −1 | 1 | 0 | 9.51 | 9.56 | −0.05 |
| 1 | 5 | −1 | −1 | 0 | 0 | 8.71 | 8.78 | −0.07 |
| 17 | 6 | −1 | 0 | −1 | 0 | 3.69 | 3.60 | 0.09 |
| 9 | 7 | −1 | 0 | 0 | −1 | 8.97 | 9.04 | −0.07 |
| 3 | 8 | −1 | 1 | 0 | 0 | 7.53 | 7.67 | −0.13 |
| 8 | 9 | 0 | 0 | 1 | 1 | 8.46 | 8.33 | 0.12 |
| 12 | 10 | 1 | 0 | 0 | 1 | 8.83 | 8.83 | 0.01 |
| 4 | 11 | 1 | 1 | 0 | 0 | 8.67 | 8.43 | 0.23 |
| 23 | 12 | 0 | −1 | 0 | 1 | 8.16 | 8.35 | −0.18 |
| 2 | 13 | 1 | −1 | 0 | 0 | 8.87 | 8.58 | 0.29 |
| 10 | 14 | 1 | 0 | 0 | −1 | 7.96 | 7.98 | −0.02 |
| 28 | 15 | 0 | 0 | 0 | 0 | 9.91 | 9.73 | 0.18 |
| 20 | 16 | 1 | 0 | 1 | 0 | 7.98 | 8.16 | −0.19 |
| 27 | 17 | 0 | 0 | 0 | 0 | 9.74 | 9.73 | 0.01 |
| 14 | 18 | 0 | 1 | −1 | 0 | 4.63 | 4.64 | −0.01 |
| 13 | 19 | 0 | −1 | −1 | 0 | 4.64 | 4.69 | −0.05 |
| 22 | 20 | 0 | 1 | 0 | −1 | 8.30 | 8.22 | 0.09 |
| 25 | 21 | 0 | 0 | 0 | 0 | 9.77 | 9.73 | 0.04 |
| 24 | 22 | 0 | 1 | 0 | 1 | 8.00 | 8.16 | −0.16 |
| 19 | 23 | −1 | 0 | 1 | 0 | 9.48 | 9.25 | 0.23 |
| 7 | 24 | 0 | 0 | −1 | 1 | 4.84 | 4.58 | 0.26 |
| 29 | 25 | 0 | 0 | 0 | 0 | 9.73 | 9.73 | 0.00 |
| 16 | 26 | 0 | 1 | 1 | 0 | 8.33 | 8.34 | −0.01 |
| 26 | 27 | 0 | 0 | 0 | 0 | 9.50 | 9.73 | −0.23 |
| 11 | 28 | −1 | 0 | 0 | 1 | 7.16 | 7.20 | −0.04 |
| 18 | 29 | 1 | 0 | −1 | 0 | 4.92 | 5.25 | −0.33 |
| Variable | Code | −1 | 0 | 1 | ||||
|---|---|---|---|---|---|---|---|---|
| Initial pH level | A | 4 | 4.5 | 5 | ||||
| Incubation time (min) | B | 30 | 60 | 90 | ||||
| Chitosan conc. (%) | C | 0.5 | 1 | 1.5 | ||||
| Temperature (ºC) | D | 40 | 50 | 60 | ||||
The analysis of variance (ANOVA)
The analysis of variance (ANOVA) is shown in Table 2. The determination coefficient (R2) was used to check the model's fit. The R2 values are a measure of the amount of variance in response values that can be explained by the experimental variables and the interactions between them40. The estimated value of R2 was 0.9937, and the measure of fit for the model was 99.37%, which indicates that just 0.63% of the variation in the response could not be explained by the model. The R2 value is typically in the range of 0 and 1. When the determination coefficient (R2) value is close to 1, the applied design is more effective in predicting the response41. When the R2 value of the regression model is closest to one, it means that the model predicted values are nearly close to the actual values42. The adjusted R2 value was 0.9873, whereas the predicted R2 value was 0.9671. It has been established that the regression model whose R2 value is more than 0.9 has a statistically significant correlation43. The predicted-R2 and Adjusted-R2 values must be within 20% of each other, so that we can say that there is a high significance and accuracy of the model and there is a reasonable agreement between them44.
Table 2.
Analysis of variance for chitosan nanoparticles biosynthesis using Eucalyptus globulus Labill leaves extract as affected by initial pH level, incubation period (min), chitosan concentration (%) and temperature (°C).
| Source of variance | Coefficient estimate | Sum of squares | Degrees of freedom | Mean square | F-value | P-value | |
|---|---|---|---|---|---|---|---|
| Model | Intercept | 9.73 | 99.18 | 14 | 7.08 | 156.77 | < 0.0001* |
| Linear effect | A | 0.14 | 0.24 | 1 | 0.24 | 5.24 | 0.0381* |
| B | −0.32 | 1.19 | 1 | 1.19 | 26.38 | 0.0002* | |
| C | 2.14 | 55.04 | 1 | 55.04 | 1218.01 | < 0.0001* | |
| D | −0.25 | 0.75 | 1 | 0.75 | 16.59 | 0.0011* | |
| Interaction effect | AB | 0.24 | 0.23 | 1 | 0.23 | 5.19 | 0.0389* |
| AC | −0.68 | 1.86 | 1 | 1.86 | 41.21 | < 0.0001* | |
| AD | 0.67 | 1.81 | 1 | 1.81 | 40.04 | < 0.0001* | |
| BC | −0.29 | 0.35 | 1 | 0.35 | 7.69 | 0.015* | |
| BD | 0.22 | 0.20 | 1 | 0.20 | 4.46 | 0.0532 | |
| CD | −0.26 | 0.28 | 1 | 0.28 | 6.20 | 0.0259* | |
| Quadratic effect | A2 | −0.81 | 4.20 | 1 | 4.20 | 93.04 | < 0.0001* |
| B2 | −0.56 | 2.05 | 1 | 2.05 | 45.41 | < 0.0001* | |
| C2 | −2.36 | 36.17 | 1 | 36.17 | 800.55 | < 0.0001* | |
| D2 | −0.66 | 2.86 | 1 | 2.86 | 63.19 | < 0.0001* | |
| Error effect | Lack of fit | 0.55 | 10 | 0.05 | 2.55 | 0.1902 | |
| Pure error | 0.09 | 4 | 0.02 | ||||
| R2 | 0.9937 | Std. dev | 0.21 | ||||
| Adj R2 | 0.9873 | Mean | 7.91 | ||||
| Pred R2 | 0.9671 | CV % | 2.69 | ||||
| Adeq precision | 40.10 | ||||||
F Fishers's function, P level of significance, CV coefficient of variation.
*Significant values.
Table 2 shows the F-values and P-values. P-values were calculated to assess the significance of each coefficient and the degree of the mutual interactions between various parameters. As the P-values decreased, the significance of the corresponding coefficient increased. In addition, process factors whose confidence levels were greater than or equal to 95 percent and whose P-values were less than or equal to 0.05 were considered to have a significant impact on the response45,46. The model's F-value was 156.77, as well as the P-value was less than 0.0001, indicating that the model was highly significant. P-value less than 0.05 indicates that the linear coefficients of A (initial pH value), B (incubation time), C (chitosan concentration %), and D (temperature) are significant and they might act as limiting factors with little variations in their values affecting the chitosan nanoparticles biosynthesis rate. A, B, C, and D had F-values of 5.24, 26.38, 1218.01, and 16.59, and P-values of 0.0381, 0.0002, > 0.0001, and 0.0011, respectively. All quadratic coefficients are significant (P-values of > 0.0001), with F-values of 93.04, 45.41, 800.55, and 63.19 for the initial pH value, incubation period, chitosan concentration % and temperature (°C), respectively. Moreover, the P-values of the coefficients reveal that, among the four factors tested, the interaction between initial pH and temperature (P-value < 0.0001) is the strongest, followed by the interaction between initial pH and chitosan concentration percent.
Signs of the coefficients were applied to interpret the data (positive or negative effect on the response)47. On the basis of the calculated coefficients (Table 2), linear effects (B, D), mutual interactions (AC, BC and CD), quadratic effects (A2, B2, C2 and D2) exerted negative effects on the chitosan nanoparticles biosynthesis. While, positive signs for the linear coefficients of A (initial pH value), and C (chitosan concentration %) indicated a linear effect in the increase in chitosan nanoparticles biosynthesis. The presence of a positive coefficient indicates that there is a synergistic impact being produced by the interactions between two variables. A × B, A × D and B × D affect the chitosan nanoparticles biosynthesis positively. The fact that the interactions between A × B and A × D have statistically significant positive coefficients (P < 0.05) suggests that the interactions between these variables contribute significantly to an increase in the biosynthesized chitosan nanoparticles.
The adequate precision value measures the signal-to-noise ratio; a signal-to-noise ratio greater than four is ideal and demonstrates the model's accuracy48. The current model has an adequate precision value of 40.10, indicating that it can be used to navigate the design space. The model showed mean, standard deviation and C.V. % (coefficient of variation) values of 7.91, 0.21 and 2.69; respectively (Table 2).
Table 3 show Box–Behnken design fit summary results of CNPs biosynthesis using Eucalyptus globulus Labill leaves extract. The fit summary used to choose the adequate model for CNPs biosynthesis using Eucalyptus globulus Labill leaves extract (linear, 2 factors interactions (2FI) or quadratic model). On the basis of the significance of the model terms and the insignificance of the lack of fit tests, the appropriate model is chosen. The fit summary results revealed that adequate model for chitosan nanoparticles biosynthesis is the quadratic model which is significant with P-value < 0.0001. Lack of Fit Test for the quadratic model (F-value = 2.55 and P-value = 0.1902) (Table 3). Furthermore, the model summary statistics for CNPs biosynthesis quadratic model revealed the minimum standard deviation of 0.2126 and the maximum R2 of 0.9937, adjusted R2 of 0.9873 and the highest predicted R2 of 0.9671.
Table 3.
Fit summary for Box–Behnken design results for chitosan nanoparticles biosynthesis using Eucalyptus globulus Labill leaves extract as affected by chitosan concentration (%), initial pH level, temperature (°C) and incubation period (min).
| Lack of fit tests | |||||
|---|---|---|---|---|---|
| Source | Sum of squares | Df | Mean square | F-value | P-value |
| Linear | 42.51 | 20 | 2.13 | 99.1 | 0.0002* |
| 2FI | 37.77 | 14 | 2.70 | 125.79 | 0.0001* |
| Quadratic | 0.55 | 10 | 0.05 | 2.55 | 0.1902 |
| Fit summary | |||||
|---|---|---|---|---|---|
| Source | P-value | R2 | Adjusted R2 | Predicted R2 | |
| Linear | 0.0003* | 0.5733 | 0.5021 | 0.4135 | |
| 2FI | 0.8852 | 0.6207 | 0.41 | 0.1147 | |
| Quadratic | < 0.0001* | 0.9937 | 0.9873 | 0.9671 | Suggested |
df degree of freedom, 2FI two factors interaction.
*Significant values.
In order to explore the relationship between independent and dependent variables, a polynomial equation of the second order was used. This equation was used to determine the optimum levels of initial pH (A), incubation time (B), chitosan concentration (C), and temperature (D), as well as the highest CNPs biosynthesis that corresponded to these optimum levels. By using multiple regression analysis to the collected experimental results, the following second-order polynomial equation defining the predicted CNPs biosynthesis (Y) regarding the independent variables (A, B, C, and D) was obtained:
| 2 |
In which Y is the predicted CNPs biosynthesis, A is the value of the initial pH level, B is the incubation time value, C is the chitosan concentration value and D is value of temperature.
The three-dimensional (3-D) surface plot
The three-dimensional response surface graphs were generated for determination of the pairwise interaction effects between the independent variables (initial pH level, incubation time, chitosan concentration and temperature) as well as the optimal levels of the variables for maximum CNPs biosynthesis (Fig. 2). Kamat et al.49 reported that the size, distribution, and number of synthesized particles are controlled by parameters such as temperature, time, and reactant concentration. CNPs biosynthesis (mg/mL) was represented on Z-axis versus two independent factors while the levels of the other two variables were fixed at their center (zero) level to achieve the optimal conditions for maximum CNPs biosynthesis using Eucalyptus globulus Labill leaves extract. Three-dimensional surface plots of CNPs biosynthesis using Eucalyptus globulus Labill leaves extract (Fig. 2A–E), illustrates the interacting effects of four evaluated variables.
Figure 2.
Three-dimensional surface plot for chitosan nanoparticles biosynthesis using Eucalyptus globulus Labill leaves extract.
The 3D surface graphs (Fig. 2A–C) illustrated the effect of initial pH level on CNPs biosynthesis when interacting with the other three variables: incubation time, chitosan concentration % and temperature; respectively. The plots reveal that the CNPs biosynthesis increased by the increasing of initial pH level. Maximum CNPs biosynthesis was obtained toward the center point of initial pH level (around 4.32). Further increase or decrease led to the decrease in the CNPs biosynthesis. Sathiyabama et al.50 prepared CNPs at a pH of 4.8.
Figure 2A,D,E represents the three-dimensional response surface plots as function of the incubation period on the CNPs biosynthesis when interacting with the other three variables: initial pH level, chitosan concentration % and temperature; respectively. The plots reveal that the CNPs biosynthesis increased by the increasing of incubation period. Maximum CNPs biosynthesis was obtained toward the center point of incubation period (around 41.62 min). Further increase or decrease led to the decrease in the CNPs biosynthesis. Our findings are in agreement with those of El-Naggar et al.19 who reported that the highest CNP biosynthesis using P. graveolens leaves extract was estimated to be 9.73 mg/mL after 57.53 min. Oliveira et al.51 found that the incubation period of 12 h is a reasonably suitable time. Saifful and Shahidan52 reported that the extension of incubation time to 18 h produced a greater average size of nanoparticles compared with the shorter time (2 h). Sathiyabama et al.50 prepared CNPs at a chitosan concentration of 0.5% (w/v) with the shorter time of 30 min of magnetic stirring.
On the other hand, Fig. 2B,D depicts the three-dimensional response surface plots as function of the chitosan concentration % on the CNPs biosynthesis when interacting with the other variables: initial pH level and incubation period; respectively. The plots reveal that the CNPs biosynthesis increased as chitosan concentration % increased to the optimal level. Maximum CNPs biosynthesis (9.91 mg/mL) was obtained toward the high level of chitosan concentration % (around 1.29%). Further increase led to the decrease in the CNPs biosynthesis. Vaezifar et al.53 found that the optimal initial chitosan concentration was 1.295 mg/mL, chitosan concentration strongly effects the size and formation of the nanoparticles. Handani et al.54 reported that the concentration of chitosan has a significant effect on the size of the nanoparticles formed. Kamat et al.49 reported that the greatest yield of nanoparticles was obtained with 0.8 mg/mL chitosan. Mahmoud et al.55 prepared CNPs at a concentration 2%. Sathiyabama et al.50 used chitosan concentration of 0.5%.
Figure 2C,E depicts the three-dimensional response surface plots as function of temperature on the CNPs biosynthesis when interacting with the other variables: initial pH level and incubation period; respectively. The plots reveal that the CNPs biosynthesis increased as temperature increased to the optimal level. Maximum CNPs biosynthesis (9.91 mg/mL) was obtained toward the low level of temperature (around 43.18%). The synthesis of nanoparticles decreases as the temperature increases. Handani et al.54 results showed that the temperature in ionic gelation method has no effect on the initial size of the nanoparticles formed. The temperature plays a key role in particle development, and shape/size control, it can significantly affect reaction rate, and hence the particle characteristics56. Kamat et al.49 reported that the greatest yield of chitosan nanoparticles was obtained at 35 °C.
The model's adequacy
The normal probability plot (NPP) of the residuals is an important graphical technique represents the residual distribution to check the model's adequacy57. In the normal probability of the experimental residuals, as shown in Fig. 3A, the data points collected closely along the straight line, indicating that the residuals follow the normal distribution. The residuals are the variation between the predicted CNPs biosynthesis values by the theoretical model and the experimental values of the CNPs biosynthesis. A small residual value indicates that the model prediction is accurate and the model was well fitted with the experimental results.
Figure 3.
(A) Normal probability plot of internally studentized residuals, (B) Box–Cox plot of model transformation, (C) plot of predicted versus residuals, and (D) plot of internally studentized actual values versus predicted values of for chitosan nanoparticles biosynthesis using Eucalyptus globulus Labill leaves extract.
Figure 3B represents the Box–Cox plot generated by the model transformation for the biosynthesis of chitosan nanoparticles. As shown in Fig. 3B, the green line represents the best lambda value (λ = 0.47) and the blue line representing the current Lambda (λ = 1). Whereas the red lines represent the minimum and maximum values of the 95% confidence interval, which are -0.1 and 1.23; respectively. The model is in the optimal zone because the blue line of the current Lambda lies between the two vertical red lines. This indicates that the model fits the obtained experimental results well and that no data transformation is required58.
In Fig. 3C, the residuals are plotted against the predicted values for the biosynthesis of chitosan nanoparticles. As shown in the graph, the residuals were scattered in a random pattern all around the zero line.
The residuals were scattered equally and randomly above and below the zero line, indicating that the residuals had a constant variance and supporting the model's precision59.
Figure 3D depicts a plot of predicted versus actual chitosan nanoparticles biosynthesis. Figure 3D shows all points were collected along the diagonal line, indicating a significant correlation between the theoretical values that were predicted by the model and the actual results of the chitosan nanoparticles biosynthesis which confirms the accuracy of the model60.
The desirability function
The purpose of the desirability function and experimental design was to determine the optimal predicted conditions for maximizing the response. The desirability function values ranged from 0 (undesirable) to 1 (desirable)61. The desirability function value is often determined mathematically prior to experimental validation of the optimization process19. In this study, the predicted values obtained for the tested variables were as the following: incubation time (41.62 min), temperature (43.18 °C), initial pH level (4.32) and chitosan concentration (1.29%). The maximum predicted value of biosynthesized CNPs was 10.53 mg/mL (Supplementary Fig. S2).
Characterization of the biosynthesized chitosan nanoparticles by SEM, TEM and EDX
Figure 4A–D depicts an investigation of the morphology of biosynthesized chitosan nanoparticles using SEM and TEM, respectively. The morphology of all nanoparticles was relatively homogeneous, with a quite consistent particle size distribution and spherical in shape. The SEM analysis indicates spherical particles with a smooth surface. While, TEM analysis of the obtained biosynthesized chitosan nanoparticles reveals particles ranging in size between 6.92 and 10.10 nm, the particles are spherical. Comparing this study to earlier ones, the biosynthesized CNPs made from an aqueous extract of fresh Eucalyptus globulus Labill leaves have the smallest particle sizes. The SEM micrograph of chitosan nanoparticles in Wardani et al.62 study reveals a rough surface morphology and the spheres have diameters around 500 nm. Using FE-SEM, Khanmohammadi et al.63 found that the synthesized CNPs have average particle sizes ranging from 33.64 to 74.87 nm. According to the findings of Van et al.16, chitosan nanoparticles created by spray drying had a size distribution of 300 to 1500 nm, with an average size of 420 nm, between 500 and 2500 nm, with an average size of 750 nm and the chitosan nanoparticles ranged in size from 700 to 3500 nm, with a mean size of 970 nm, depending on the hole diameter of the spray cap. Bodnar et al.64 reported that the range of the TEM-measured particle size was 60 to 280 nm. In Dudhani et al.65 study, the chitosan nanoparticles size was 110 ± 5 nm. Zhang et al.66 prepared chitosan nanoparticles with size range between 100 and 400 nm.
Figure 4.
(A,B) SEM micrographs, (C,D) TEM micrograph of chitosan nanoparticles biosynthesised using Eucalyptus globulus Labill leaves extract.
The EDX spectrum analysis of the biosynthesized chitosan nanoparticles detected the presence of: carbon (C), oxygen (O) and nitrogen (N), as main elements in chitosan nanoparticles as shown in Fig. 5A.
Figure 5.
(A) EDX, (B) XRD, (C) FTIR, (D) zeta potential, (E) DSC and (F) TGA analyses of chitosan nanoparticles biosynthesised using Eucalyptus globulus Labill leaves extract.
X-ray diffraction (XRD)
An X-ray diffraction pattern was used to recognize the crystal phases of the materials. X-ray diffraction was used to detect the crystallinity of CNPs as shown in Fig. 5 B. The XRD pattern of the dried CNPs was recorded at angles within the range of 10°–40° (2θ) with time per step 132 s, generator tension of 30 kV, generator current of 10 mA, and temperature of 23.7 °C. The XRD pattern of CNPs sample showed three distinctive peaks at 2θ which were at 10.86, 20.74 and 30.78° (Fig. 5B) indicating a shift from the normal chitosan peaks. The crystalline structure of chitosan nanoparticles was demonstrated by XRD patterns that displayed strong peak at angle of 20.74° (Fig. 5B).
Similar results were obtained by Rasaee et al.67, they reported that the CNPs showed a weak diffraction characteristic peak at 2θ = 10° and a strong diffraction characteristic peak at 2θ = 20°, revealing the high degree of chitosan crystallinity. The spectrum exhibits a large diffraction peak at 2θ = 20°, which was identified as the predominant diffraction peak of (110) chitosan68. In the XRD diffraction patterns of the chitosan and chitosan nanoparticles, the diffraction peaks at 2θ of 10.18° and 20.26° were observed. Each of these diffraction peaks is a reflection of the (020) hydrated crystalline structure and (110) crystalline structure of anhydrous α-chitin69. This indicates the presence of a crystalline phase in the synthesized chitosan nanoparticles69. Chitosan's diffraction pattern has peaks at 2θ = 9.28° and 20.18°, showing its crystalline form II and a broad band was seen at 2θ = 30°10. Peaks seen at 2θ = 20° and 2θ = 10° are typical of chitosan70. The diffraction peak around 2θ ≈ 30° is indicative of residual chitin in commercial chitosan13. On the other hand, Olajire et al.71 reported that the peak near 2θ = 30º might be an indication of the presence of some inorganic materials that are left behind in the chitosan sample. The XRD pattern of the biosynthesised CNPs showed no peak at 2θ = 16° which is the characteristic feature corresponding to the amorphous structure72.
Fourier transforms infrared (FTIR) measurements
FTIR analysis is a powerful tool revealed various functional groups of organic compounds. Figure 5C and Table 4 shows the FTIR spectrum of CNPs in 4000–500 cm−1 range for analysis of functional groups present in their structure. FTIR spectrum has several peaks, the first at 564 cm−1 which represents out-of-plane bending NH and out-of-plane bending C−O73. The absorption peaks at 644 cm−1 attributed to the vibration of –C≡CH74. The peaks between 1000 and 1050 cm−1 refers to the stretching vibrations of C–OH and C–O–C75. Peaks at 1265–1064 cm−1 are related to in-plane O–H bending of aromatic compounds, this functional group due to the presence of flavones, terpenoids and polysaccharides compounds in the aqueous leaves extract76. The peak at 1412 cm−1 represents C–N stretching vibrations (amide III band)77. The peak at 1568 cm−1 represents –NH2 bending vibration78. The peak at 1634 cm−1 refers to amide I group79. The C–O and C–C stretching absorbance peak at 1879 cm−1 is related to the release of gaseous compounds that contain aldehyde or ketone or organic acid or alkene groups80. The peak at 2360 cm−1 is due to CO2 bending vibrations81. The peak at 2934 cm−1 is attributed to aromatic C-H bending vibration82. The peak at 3429 cm−1 is resulting from O–H stretching83. The observed peaks between 3400 and 3800 cm−1 are attributed to the O–H, NH2 bending vibration, and intramolecular hydrogen bonding84. O–H stretching in carboxylic acids is responsible for the peak at 3881 cm−185.
Table 4.
FTIR peaks of biosynthesized chitosan nanoparticles with the annotations and references of each peak.
| No | Wave no. (cm−1) | Annotations | References |
|---|---|---|---|
| 1 | 564 | Out-of-plane bending NH, out-of-plane bending C−O | Varma and Vasudevan73 |
| 2 | 644 | –C≡CH | Tan et al.74 |
| 3 | 1050 | C–OH/C–O–C bonds | Vasilev et al.75 |
| 4 | 1206 | In-plane O–H bending of aromatic compounds | Olajire et al.76 |
| 5 | 1412 | C–N (amide III band) | Uzun and Topal77 |
| 6 | 1568 | –NH2 | Rajam et al.78 |
| 7 | 1634 | Amide I group | Azeez, et al.79 |
| 8 | 1879 | Release of gaseous compounds | Liu et al.80 |
| 9 | 2360 | CO2 | Praffulla et al.81 |
| 10 | 2934 | Aromatic C–H stretching | Kunasekaran, et al.82 |
| 11 | 3429 | O–H stretching | Kumirska, et al.83 |
| 12 | 3797 | O–H, NH2 | Damiri et al.84 |
| 13 | 3881 | O–H stretching in carboxylic acid | Anandalakshmi et al.85 |
Zeta potential
The zeta potential value was used to estimate the surface charge and thus the stability of the synthesized nanoparticles. In this study; the zeta potential value on the CNPs surface was + 31.1 mV indicating that the CNPs have high stability due to higher electrostatic repulsion (Fig. 5D). Kheiri et al.86 reported that zeta potentials of the nanoparticles formed were positive due to residual protonated amine groups. Despite the fact that the suspension is physically stable, Muller et al.87 and Manikandan & Sathiyabama88 mentioned that a zeta potential of at least ± 30 mV is necessary as minimum for a NPs suspension to be stabilized by principally by electrostatic repulsion. If the zeta potential is smaller than + 30 mV, this indicates that the CNPs have less stability due to lower electrostatic repulsion12. CNPs have a positive zeta potential, which indicates that they have a charge. According to the findings of Khan et al.89, Raza & Anwar90 and Asal et al.91, the zeta potential on the surface of CNPs was determined to be + 31 ± 3.14, + 31.3 and + 31 ± 2.2 mV; respectively. On the other hand, Qi et al.92 reported that the surfaces of chitosan nanoparticles had a positive charge around 51 mV.
Differential scanning calorimetry (DSC)
The differential scanning calorimeter, or DSC, is a frequently used thermal analytical tool that can assist in understanding the thermal behavior of polymers93. The DSC thermogram of CNPs showed two bands, which had typical polysaccharide thermal features. The first was an endothermic wide band corresponding to polymeric dehydration ranged from 39.27 to 103.79 °C. The second thermal band was polymeric degradation, causing an exothermic band extending from 218 to 237 °C as shown in Fig. 5E. Feyzioglu and Tornuk94 reported that CNPs revealed an endothermic peak at 120.2ºC and an exothermic peak at 266 °C, which indicates water evaporation and decomposition of the NPs, respectively. Also, Vijayalakshmi et al.95 described a wide endothermic peak achieved under 80 °C is outstanding for the removal of absorbed water.
Thermogravimetric analysis (TGA)
TGA is a thermal analysis technique that detects changes in chemical and physical characteristics of the materials as a function of growing temperature or as a function of time96. A thermogravimetric analyzer, model TGA-50H, was used to determine changes in the thermal characteristics of biosynthesized CNPs sample of about 6 mg. At a flow rate of 40 mL/min, the sample was scanned at temperatures ranging from room temperature to 500 °C. The TGA of CNPs is characterized by the presence of five degradation stages (Fig. 5F) at 28.21–80.22 °C, 80.68–164.4 °C, 164.4–317.60 °C, 317.6–372.63 °C, and 372.63–499.95 °C, showing percentage loss values equal to 7.244%, 5.064%, 26.178%, 7.376%, and 9.247%, respectively. These weight losses indicated partial thermal disintegration of CNPs. At heating temperature (500 °C), the total loss was 55.1%57. According to Sivakami et al.97 findings, the weight loss that occurs between 50 and 150 °C is caused by the evaporation of water, whereas the weight loss that occurs between 200 and 350 °C is due to the heat degradation of chitosan nanoparticles.
On the other hand, Morsy et al.98 reported that the TGA diagram of chitosan nanoparticles showed the initial weight loss of 8.56% at 100 °C. This loss is related to the evaporation of intra and inter-molecular moisture in the CNPs. When heated at 200 °C, CNPs had a weight loss of 11.96%, which is consistent with the thermal decomposition of functional groups, such as OH, located on the chitosan backbone. The heat degradation of the chitosan backbone was responsible for the weight loss of 29.17% to 55.38% that occurred between 300 and 500 °C.
Antibacterial activity of CNPs of against multi-drug resistant A. baumannii
Multi-drug resistant bacteria Acinetobacter baumannii complex was used to carry out the antibacterial activity tests of CNPs with concentrations of 12.5, 25 and 50 mg/mL. After incubation for 24 h, the inhibition zone diameter created by the well containing CNPs was recorded: 12, 16, 30 mm diameter, respectively. As shown in Fig. 6. The inhibition of bacterial growth increased as CNPs concentrations increased.
Figure 6.
Antibacterial activity of different concentrations of chitosan nanoparticles produced using Eucalyptus leaves extract against Acinetobacter baumannii.
TEM examination of the effect of CNPs on multi-drug resistant A. baumannii cells
The antibiotic resistance of A. baumannii complex is becoming increasingly serious. Colistin and Polymyxin, that target the cell membrane, are thought to be the final line of defense against drug-resistant bacteria, but they come with a lot of side effects, and drug resistance to these drugs is increasing gradually99. This study tried to control the growth of multi-drug resistant A. baumannii complex using biosynthesized CNPs. To study the changes in the morphology of A. baumannii complex cells treated with CNPs. The control (untreated) cells of A. baumannii complex were represented in Fig. 7A, in which a well-defined cell membrane was seen (the inner and outer membrane envelopes were smooth). The cytoplasmic content of the bacterial cell was regularly distributed. Compared with untreated cells, considerable morphological variations were detected in A. baumannii complex cells treated with CNPs. As shown in Fig. 7B a great number of CNPs were detected around the bacterial cell membrane. The damage in the cell membrane and the cytoplasm content leaked to the extracellular medium with increases in the periplasmic space (black arrow head) (Fig. 7C–E) the bacterial cells outer membrane is enlarged and evacuated from the plasma membrane. In addition, coagulated material was observed in the cytoplasm. Figure 7F Due to the loss of most cytoplasmic contents from the inner membrane, the outer membrane is enlarged and evacuated, resulting in complete membrane loss; ghost cells100.
Figure 7.
TEM examination of the effect of CNPs on multi-drug resistant A. baumannii cells: (A) cells of untreated bacteria, (B–F) cells of bacteria treated with CNPs with different stages in damage and (G) mechanisms of antibacterial action of CNPs.
Mechanisms of antibacterial action of CNPs
Several studies on chitosan nanoparticles revealed the stronger antibacterial activity of CNPs against Gram-negative and Gram-positive bacteria, Fig. 7G explain the antibacterial actions of CNPs. The presence of amine groups (NH3+) in glucosamine provides chitosan its polycationic nature, which may be a significant function in its ability to attach with negatively charged surface components of many microorganisms, causing wide variations to the cell surface and subsequent leakage of intracellular substances, resulting in cell death101. Chitosan nanoparticles have the properties of chitosan as well as the benefits of nanoparticles. The unique properties of nanoparticles, such as their small size and quantum effects, can offer chitosan nanoparticles with higher capabilities. This is due to the fact that the characteristics of bulk materials stay relatively constant regardless of volume; but, as their size reduces, the percentage of surface atoms increase, creating nanoparticles with some remarkable characteristics102. Avadi et al.103 also mentioned the chitosan nanoparticles higher antibacterial activity than bulk chitosan due to the polycationic chitosan nanoparticles with a higher surface charge density interact with bacteria more effectively than chitosan. For a quantum-size impact, chitosan nanoparticles provide a stronger affinity towards bacteria cells. Chitosan nanoparticles are able to provide significant antimicrobial properties through various mechanisms. 4 mechanisms have been suggested to describe how chitosan attach to the surface of Gram-negative bacteria (either the outer membrane or the cell wall) affecting their antimicrobial activity: (a) Positively charged chitosan interacts with negatively charged residues on the bacterial surface to modify cell permeability through an electrostatic interaction; (b) Chitosan penetrates through the cell membrane and adsorb onto the DNA molecules leading to blocking the transcription of RNA, inhibition of mRNA synthesis and protein synthesis102,104; (c) Chitosan inhibits microbial growth by chelating essential nutrients and minerals. Smaller molecules like potassium and phosphate seep out, followed by larger molecules like RNA and DNA etc.105. Chandrasekaran106 reported that chitosan nanoparticles have metallic ion chelation property which is a possible reason for its antimicrobial action; (d) Chitosan has the ability to create a polymer film on the cell surface, which acts as a barrier to oxygen and prevents nutrients from entering the cell, inhibiting aerobic bacterial growth107. Nanoparticles have a greater affinity to produce excess quantities of reactive oxygen species (ROS). Due to the strong oxidation potential, additional ROS produced by nanoparticles can damage biomolecules and organelle components and cause oxidative carbonyl of protein, fat peroxide, DNA/RNA fracture, and destruction of membrane structure, leading to more necrosis, apoptosis or even mutations108. Dizaj et al.109 described that the antimicrobial activity of nanostructured materials (NSM) includes the creation of reactive oxygen species (ROS) which induces an increase in oxidative stress in microbial cells. Highly elevated amounts of reactive oxygen species (ROS) and other free radicals cause mitochondrial and endoplasmic reticulum disorder, along with severe damages to biomolecules, resulting in genotoxic effects.
Conclusions
In this study CNPs have been biologically synthesized and characterized, the CNPs obtained have small particle size with a regular spherical shape and positive surface charges, the antibacterial experiment indicated that the CNPs exhibited excellent antibacterial properties against Acinetobacter baumannii complex. The biologically synthesized CNPs could be suitable for biological applications in medical treatments and food preservation. Nevertheless, CNP's mechanisms of action against bacteria have not yet been fully elucidated. Therefore, investigations on the antibacterial mechanisms of CNPs and toxicological studies are necessary.
Supplementary Information
Acknowledgements
The authors gratefully acknowledge the City of Scientific Research and Technological Applications (SRTA-City), Alexandria, 21934, Egypt, for providing financial support for laboratory measurements and analyzes of this paper within the framework of SRTA-City Central Laboratories Services. All the authors want to offer many thanks to Prof. Dr. Mohamed Fathy Azzazy, head of Surveys of Natural Resources Department, Environmental Studies and Research Institute, University of Sadat City, Egypt, for identifying the plant used in this manuscript, Eucalyptus globulus Labill.
Author contributions
N.E.E. proposed the research topic, designed the research plan, provided necessary tools for the experiments and experimental instructions, performed the statistical analysis, interpretation of the results, designed and draw the explanatory diagram (Fig. 7G), and contributed to the writing of the manuscript and critically revised the manuscript. A.M.S. performed the experiments, collected the data, analyzed and discussed the results and wrote the manuscript. H.M. and A. B.A.M. provided some tools for the experiments. All authors read and approved the final manuscript.
Funding
Open access funding provided by The Science, Technology & Innovation Funding Authority (STDF) in cooperation with The Egyptian Knowledge Bank (EKB).
Data availability
All data generated or analyzed during this study are included in this article.
Competing interests
The authors declare no competing interests.
Footnotes
Publisher's note
Springer Nature remains neutral with regard to jurisdictional claims in published maps and institutional affiliations.
Supplementary Information
The online version contains supplementary material available at 10.1038/s41598-022-24303-5.
References
- 1.Yin Y, et al. Itaconic acid grafted carboxymethyl chitosan and its nanoparticles: Preparation, characterization and evaluation. Int. J. Biol. Macromol. 2017;102:10–18. doi: 10.1016/j.ijbiomac.2017.04.005. [DOI] [PubMed] [Google Scholar]
- 2.Boroumand H, et al. Chitosan-based nanoparticles against viral infections. Front. Cell. Infect. Microbiol. 2021;11:175. doi: 10.3389/fcimb.2021.643953. [DOI] [PMC free article] [PubMed] [Google Scholar]
- 3.Wong CY, Al-Salami H, Dass CR. Formulation and characterisation of insulin-loaded chitosan nanoparticles capable of inducing glucose uptake in skeletal muscle cells in vitro. J. Drug Deliv. Sci. Technol. 2020;57:101738. [Google Scholar]
- 4.Matos BN, Reis TA, Gratieri T, Gelfuso GM. Chitosan nanoparticles for targeting and sustaining minoxidil sulphate delivery to hair follicles. Int. J. Biol. Macromol. 2015;75:225–229. doi: 10.1016/j.ijbiomac.2015.01.036. [DOI] [PubMed] [Google Scholar]
- 5.Ting DR, Shen Y. Antibacterial finishing with chitosan derivatives and their nano-particles. Dyeing Finish. 2005;14:12–14. [Google Scholar]
- 6.Maruyama CR, et al. Nanoparticles based on chitosan as carriers for the combined herbicides imazapic and imazapyr. Sci. Rep. 2016;6(1):1–15. doi: 10.1038/srep19768. [DOI] [PMC free article] [PubMed] [Google Scholar]
- 7.Namasivayam SKR, Bharani RA, Karunamoorthy K. Insecticidal fungal metabolites fabricated chitosan nanocomposite (IM-CNC) preparation for the enhanced larvicidal activity—An effective strategy for green pesticide against economic important insect pests. Int. J. Biol. Macromol. 2018;120:921–944. doi: 10.1016/j.ijbiomac.2018.08.130. [DOI] [PubMed] [Google Scholar]
- 8.Ha NMC, Nguyen TH, Wang SL, Nguyen AD. Preparation of NPK nanofertilizer based on chitosan nanoparticles and its effect on biophysical characteristics and growth of coffee in green house. Res. Chem. Intermed. 2019;45(1):51–63. [Google Scholar]
- 9.Hasheminejad N, Khodaiyan F, Safari M. Improving the antifungal activity of clove essential oil encapsulated by chitosan nanoparticles. Food Chem. 2019;275:113–122. doi: 10.1016/j.foodchem.2018.09.085. [DOI] [PubMed] [Google Scholar]
- 10.Divya K, Vijayan S, George TK, Jisha MS. Antimicrobial properties of chitosan nanoparticles: Mode of action and factors affecting activity. Fibers Polymers. 2017;18(2):221–230. [Google Scholar]
- 11.Yanat M, Schroën K. Preparation methods and applications of chitosan nanoparticles; with an outlook toward reinforcement of biodegradable packaging. React. Funct. Polym. 2021;161:104849. [Google Scholar]
- 12.Hejjaji EM, Smith AM, Morris GA. Evaluation of the mucoadhesive properties of chitosan nanoparticles prepared using different chitosan to tripolyphosphate (CS: TPP) ratios. Int. J. Biol. Macromol. 2018;120:1610–1617. doi: 10.1016/j.ijbiomac.2018.09.185. [DOI] [PubMed] [Google Scholar]
- 13.Hijazi N, et al. Chitosan nanoparticles generation using CO2 assisted processes. J. Supercrit. Fluids. 2014;95:118–128. [Google Scholar]
- 14.Mukhopadhyay P, et al. Oral insulin delivery by self-assembled chitosan nanoparticles: in vitro and in vivo studies in diabetic animal model. Mater. Sci. Eng. C. 2013;33(1):376–382. doi: 10.1016/j.msec.2012.09.001. [DOI] [PubMed] [Google Scholar]
- 15.Nguyen TV, Nguyen TTH, Wang SL, Vo TPK, Nguyen AD. Preparation of chitosan nanoparticles by TPP ionic gelation combined with spray drying, and the antibacterial activity of chitosan nanoparticles and a chitosan nanoparticle–amoxicillin complex. Res. Chem. Intermed. 2017;43(6):3527–3537. [Google Scholar]
- 16.Van SN, Minh HD, Anh DN. Study on chitosan nanoparticles on biophysical characteristics and growth of Robusta coffee in green house. Biocatal. Agric. Biotechnol. 2013;2:289–294. [Google Scholar]
- 17.Ghormade V, Deshpande MV, Paknikar KM. Perspectives for nano-biotechnology enabled protection and nutrition of plants. Biotechnol. Adv. 2011;29(6):792–803. doi: 10.1016/j.biotechadv.2011.06.007. [DOI] [PubMed] [Google Scholar]
- 18.El-Naggar NE, Saber WI, Zweil AM, Bashir SI. An innovative green synthesis approach of chitosan nanoparticles and their inhibitory activity against phytopathogenic Botrytis cinerea on strawberry leaves. Sci. Rep. 2022;12(1):1–20. doi: 10.1038/s41598-022-07073-y. [DOI] [PMC free article] [PubMed] [Google Scholar]
- 19.He S, et al. Biosynthesis of gold nanoparticles using the bacteria Rhodopseudomonas capsulata. Mater. Lett. 2007;61(18):3984–3987. [Google Scholar]
- 20.Bhainsa KC, D'souza SF. Extracellular biosynthesis of silver nanoparticles using the fungus Aspergillus fumigatus. Colloids Surf. B. 2006;47(2):160–164. doi: 10.1016/j.colsurfb.2005.11.026. [DOI] [PubMed] [Google Scholar]
- 21.Shankar SS, Rai A, Ahmad A, Sastry M. Rapid synthesis of Au, Ag, and bimetallic Au core–Ag shell nanoparticles using neem (Azadirachta indica) leaf broth. J. Colloid Interface Sci. 2004;275(2):496–502. doi: 10.1016/j.jcis.2004.03.003. [DOI] [PubMed] [Google Scholar]
- 22.Chandran SP, Chaudhary M, Pasricha R, Ahmad A, Sastry M. Synthesis of gold nanotriangles and silver nanoparticles using aloe vera plant extract. Biotechnol. Prog. 2006;22(2):577–583. doi: 10.1021/bp0501423. [DOI] [PubMed] [Google Scholar]
- 23.Batish DR, Singh HP, Kohli RK, Kaur S. Eucalyptus essential oil as a natural pesticide. For. Ecol. Manag. 2008;256:2166–2174. [Google Scholar]
- 24.El-Naggar NE, El-Bindary AA, Nour NS. Statistical optimization of process variables for antimicrobial metabolites production by Streptomyces anulatus NEAE-94 against some multidrug-resistant strains. Int. J. Pharmacol. 2013;9(6):322–334. [Google Scholar]
- 25.El-Naggar NE, Hamouda RA. Antimicrobial potentialities of Streptomyces lienomycini NEAE-31 against human pathogen multidrug-resistant Pseudomonas aeruginosa. Int. J. Pharmacol. 2016;12(8):769–788. [Google Scholar]
- 26.El-Naggar NE, El-Bindary AAA, Abdel-Mogib M, Nour NS. In vitro activity, extraction, separation and structure elucidation of antibiotic produced by Streptomyces anulatus NEAE-94 active against multidrug-resistant Staphylococcus aureus. Biotechnol. Biotechnol. Equip. 2017;31(2):418–430. [Google Scholar]
- 27.El-Naggar NEA, El-Bindary AA, Nour NS. Production of antimicrobial agent inhibitory to some human pathogenic multidrug-resistant bacteria and Candida albicans by Streptomyces sp. NEAE-1. Int. J. Pharmacol. 2013;9(6):335–347. [Google Scholar]
- 28.Kröger C, Kary SC, Schauer K, Cameron AD. Genetic regulation of virulence and antibiotic resistance in Acinetobacter baumannii. Genes. 2017;8(1):12. doi: 10.3390/genes8010012. [DOI] [PMC free article] [PubMed] [Google Scholar]
- 29.Pourhajibagher M, Hosseini N, Boluki E, Chiniforush N, Bahador A. Photoelimination potential of chitosan nanoparticles-indocyanine green complex against the biological activities of Acinetobacter baumannii strains: A preliminary in vitro study in burn wound infections. J. Lasers Med. Sci. 2020;11(2):187. doi: 10.34172/jlms.2020.31. [DOI] [PMC free article] [PubMed] [Google Scholar]
- 30.Gui S, Li R, Feng Y, Wang S. Transmission electron microscopic morphological study and flow cytometric viability assessment of Acinetobacter baumannii susceptible to Musca domestica cecropin. Sci. World J. 2014;2014:1–6. doi: 10.1155/2014/657536. [DOI] [PMC free article] [PubMed] [Google Scholar]
- 31.El-Naggar NE, Haroun SA, Owis EA, Sherief AA. Optimization of β-glucosidase production by Aspergillus terreus strain EMOO 6-4 using response surface methodology under solid-state fermentation. Prep. Biochem. Biotechnol. 2015;45(6):568–587. doi: 10.1080/10826068.2014.940968. [DOI] [PubMed] [Google Scholar]
- 32.El-Naggar NE, Moawad H, El-Shweihy NM, El-Ewasy SM. Optimization of culture conditions for production of the anti-leukemic glutaminase free l-asparaginase by newly isolated Streptomyces olivaceus NEAE-119 using response surface methodology. BioMed Res. Int. 2015;2015(627031):1–17. doi: 10.1155/2015/627031. [DOI] [PMC free article] [PubMed] [Google Scholar]
- 33.El-Naggar NE, Mohamedin AH, Sherief AA, Hussien SM. Optimization of fermentation conditions for production of bioactive metabolites effective against Staphylococcus epidermidis by a newly isolated Nocardiopsis chromatogenes strain SH89 using the response surface methodology. Global J. Pure Appl. Sci. 2016;10(1):823–839. [Google Scholar]
- 34.Bekmukhametova A, et al. Fabrication and characterization of chitosan nanoparticles using the coffee-ring effect for photodynamic therapy. Lasers Surg. Med. 2022;54:758–766. doi: 10.1002/lsm.23530. [DOI] [PubMed] [Google Scholar]
- 35.Sharifi-Rad J, Quispe C, Butnariu M, Rotariu LS, Sytar O, Sestito S, Calina D. Chitosan nanoparticles as a promising tool in nanomedicine with particular emphasis on oncological treatment. Cancer Cell Int. 2021;21(1):1–21. doi: 10.1186/s12935-021-02025-4. [DOI] [PMC free article] [PubMed] [Google Scholar]
- 36.Box GE, Behnken DW. Some new three level designs for the study of quantitative variables. Technometrics. 1960;2(4):455–475. [Google Scholar]
- 37.AminiTapouk F, et al. Comparative efficacy of hospital disinfectants against nosocomial infection pathogens. Antimicrob. Resist. Infect. Control. 2020;9(1):1–7. doi: 10.1186/s13756-020-00781-y. [DOI] [PMC free article] [PubMed] [Google Scholar]
- 38.Tahmasebi, et al. Three-dimensional stochastic characterization of shale SEM images. Transp. Porous Media. 2015;110(3):521–531. [Google Scholar]
- 39.Agnihotri SA, Mallikarjuna NN, Aminabhavi TM. Recent advances on chitosan-based micro-and nanoparticles in drug delivery. J. Control. Release. 2004;100(1):5–28. doi: 10.1016/j.jconrel.2004.08.010. [DOI] [PubMed] [Google Scholar]
- 40.Mohamedin A, El-Naggar NE, Shawqi Hamza S, Sherief AA. Green synthesis, characterization and antimicrobial activities of silver nanoparticles by Streptomyces viridodiastaticus SSHH-1 as a living nanofactory: Statistical optimization of process variables. Curr. Nanosci. 2015;11(5):640–654. [Google Scholar]
- 41.El-Naggar NE. Isolation, screening and identification of actinobacteria with uricase activity: Statistical optimization of fermentation conditions for improved production of uricase by Streptomyces rochei NEAE–25. Int. J. Pharmacol. 2015;11:644–658. [Google Scholar]
- 42.El-Naggar NE, El-Shweihy NM, El-Ewasy SM. Identification and statistical optimization of fermentation conditions for a newly isolated extracellular cholesterol oxidase-producing Streptomyces cavourensis strain NEAE-42. BioMed Central Microbiol. 2016;16(1):1–20. doi: 10.1186/s12866-016-0830-4. [DOI] [PMC free article] [PubMed] [Google Scholar]
- 43.El-Naggar NE, Hussein MH, El-Sawah AA. Phycobiliprotein-mediated synthesis of biogenic silver nanoparticles, characterization, in vitro and in vivo assessment of anticancer activities. Sci. Rep. 2018;8(1):1–20. doi: 10.1038/s41598-018-27276-6. [DOI] [PMC free article] [PubMed] [Google Scholar]
- 44.El-Naggar NE, Rabei NH. Bioprocessing optimization for efficient simultaneous removal of methylene blue and nickel by Gracilaria seaweed biomass. Sci. Rep. 2020;10(1):1–21. doi: 10.1038/s41598-020-74389-y. [DOI] [PMC free article] [PubMed] [Google Scholar]
- 45.El-Naggar NE, Rabei NH, El-Malkey SE. Eco-friendly approach for biosorption of Pb2+ and carcinogenic Congo red dye from binary solution onto sustainable Ulva lactuca biomass. Sci. Rep. 2020;10(1):1–22. doi: 10.1038/s41598-020-73031-1. [DOI] [PMC free article] [PubMed] [Google Scholar]
- 46.El-Naggar NE, El-Khateeb AY, Ghoniem AA, El-Hersh MS, Saber WI. Innovative low-cost biosorption process of Cr6+ by Pseudomonas alcaliphila NEWG-2. Sci. Rep. 2020;10:1–18. doi: 10.1038/s41598-020-70473-5. [DOI] [PMC free article] [PubMed] [Google Scholar]
- 47.El-Naggar NE, El-Shweihy NM. Bioprocess development for l-asparaginase production by Streptomyces rochei, purification and in-vitro efficacy against various human carcinoma cell lines. Sci. Rep. 2020;10(1):1–21. doi: 10.1038/s41598-020-64052-x. [DOI] [PMC free article] [PubMed] [Google Scholar]
- 48.El-Naggar NE, Hamouda RA, El-Khateeb AY, Rabei NH. Biosorption of cationic Hg2+ and Remazol brilliant blue anionic dye from binary solution using Gelidium corneum biomass. Sci. Rep. 2021;11(1):1–24. doi: 10.1038/s41598-021-00158-0. [DOI] [PMC free article] [PubMed] [Google Scholar]
- 49.Kamat V, Bodas D, Paknikar K. Chitosan nanoparticles synthesis caught in action using microdroplet reactions. Sci. Rep. 2016;6(1):1–4. doi: 10.1038/srep22260. [DOI] [PMC free article] [PubMed] [Google Scholar]
- 50.Sathiyabama M, Parthasarathy R. Biological preparation of chitosan nanoparticles and it's invitro antifungal efficacy against some phytopathogenic fungi. Carbohyd. Polym. 2016;151:321–325. doi: 10.1016/j.carbpol.2016.05.033. [DOI] [PubMed] [Google Scholar]
- 51.de Oliveira HP, Tenorio AC, de Lima EG, de Melo CP. Dielectric characterization of colloidal solutions of retinoic acid embedded in microspheres of polyvinyl alcohol. Colloids Surf. A. 2005;257:3–7. [Google Scholar]
- 52.Saifful KM, Shahidan R. Incubation effect on zinc oxide nanoparticles produced using colloidal gas aphrons. Sains Malays. 2011;40(5):503–509. [Google Scholar]
- 53.Vaezifar S, Razavi S, Golozar MA, Karbasi S, Morshed M, Kamali M. Effects of some parameters on particle size distribution of chitosan nanoparticles prepared by ionic gelation method. J. Cluster Sci. 2013;24(3):891–903. [Google Scholar]
- 54.Handani, W. R., Sediawan, W. B., Tawfiequrrahman, A., Wiratni, & Kusumastuti, Y. The effect of temperature and chitosan concentration during storage on the growth of chitosan nanoparticle produced by ionic gelation method. in AIPConferenceProceedings. Vol. 1840(1). 080001 (2017).
- 55.Mahmoud ME, Abou Kana MT, Hendy AA. Synthesis and implementation of nano-chitosan and its acetophenone derivative for enhanced removal of metals. Int. J. Biol. Macromol. 2015;81:672–680. doi: 10.1016/j.ijbiomac.2015.08.063. [DOI] [PubMed] [Google Scholar]
- 56.Jiang XC, Chen WM, Chen CY, Xiong SX, Yu AB. Role of temperature in the growth of silver nanoparticles through a synergetic reduction approach. Nanoscale Res. Lett. 2011;6(1):1–9. doi: 10.1007/s11671-010-9780-1. [DOI] [PMC free article] [PubMed] [Google Scholar]
- 57.El-Naggar NE, Soliman HM, El-Shweihy NM. Extracellular cholesterol oxidase production by Streptomyces aegyptia, in vitro anticancer activities against rhabdomyosarcoma, breast cancer cell-lines and in vivo apoptosis. Sci. Rep. 2018;8(1):1–18. doi: 10.1038/s41598-018-20786-3. [DOI] [PMC free article] [PubMed] [Google Scholar]
- 58.El-Naggar NE, Hussein MH, El-Sawah AA. Bio-fabrication of silver nanoparticles by phycocyanin, characterization, in vitro anticancer activity against breast cancer cell line and in vivo cytotxicity. Sci. Rep. 2017;7(1):1–20. doi: 10.1038/s41598-017-11121-3. [DOI] [PMC free article] [PubMed] [Google Scholar]
- 59.El-Naggar NE, Haroun SA, El-Weshy EM, Metwally EA, Sherief AA. Mathematical modeling for bioprocess optimization of a protein drug, uricase, production by Aspergillus welwitschiae strain 1–4. Sci. Rep. 2019;9(1):1–15. doi: 10.1038/s41598-019-49201-1. [DOI] [PMC free article] [PubMed] [Google Scholar]
- 60.El-Naggar NE, Moawad H, Abdelwahed NA. Optimization of fermentation conditions for enhancing extracellular production of l-asparaginase, an anti-leukemic agent, by newly isolated Streptomyces brollosae NEAE-115 using solid state fermentation. Ann. Microbiol. 2017;67(1):1–15. [Google Scholar]
- 61.El-Naggar NE, Hamouda RA, Saddiq AA, Alkinani MH. Simultaneous bioremediation of cationic copper ions and anionic methyl orange azo dye by brown marine alga Fucus vesiculosus. Sci. Rep. 2021;11(1):1–19. doi: 10.1038/s41598-021-82827-8. [DOI] [PMC free article] [PubMed] [Google Scholar]
- 62.Wardani G, Sudjarwo SA. In vitro antibacterial activity of chitosan nanoparticles against Mycobacterium tuberculosis. Pharmacogn. J. 2018;10(1):162–166. [Google Scholar]
- 63.Khanmohammadi M, Elmizadeh H, Ghasemi K. Investigation of size and morphology of chitosan nanoparticles used in drug delivery system employing chemometric technique. Iran. J. Pharmaceut. Res. (IJPR) 2015;14(3):665. [PMC free article] [PubMed] [Google Scholar]
- 64.Bodnar M, Hartmann JF, Borbely J. Preparation and characterization of chitosan-based nanoparticles. Biomacromol. 2005;6(5):2521–2527. doi: 10.1021/bm0502258. [DOI] [PubMed] [Google Scholar]
- 65.Dudhani AR, Kosaraju SL. Bioadhesive chitosan nanoparticles: Preparation and characterization. Carbohyd. Polym. 2010;81(2):243–251. [Google Scholar]
- 66.Zhang HL, Wu SH, Tao Y, Zang LQ, Su ZQ. Preparation and characterization of water-soluble chitosan nanoparticles as protein delivery system. J. Nanomater. 2010;2010(898910):5. [Google Scholar]
- 67.Rasaee I, Ghannadnia M, Honari H. Antibacterial properties of biologically formed chitosan nanoparticles using aqueous leaf extract of Ocimum basilicum. Nanomed. J. 2016;3(4):240–247. [Google Scholar]
- 68.Anusha JR, Fleming AT. Synthesis and characterization of chitosan nanoaggregates from gladius of Uroteuthis duvauceli. Int. J. Biomater. 2016;2016(5379424):1–9. doi: 10.1155/2016/5379424. [DOI] [PMC free article] [PubMed] [Google Scholar]
- 69.Budi S, Suliasih BA, Rahmawati I. Size-controlled chitosan nanoparticles prepared using ionotropic gelation. Sci. Asia. 2020;46(4):457–461. [Google Scholar]
- 70.Chesnutt BM, et al. Design and characterization of a novel chitosan/nanocrystalline calcium phosphate composite scaffold for bone regeneration. J. Biomed. Mater. Res. Part A. 2009;88(2):491–502. doi: 10.1002/jbm.a.31878. [DOI] [PubMed] [Google Scholar]
- 71.Olajire AA, Bamigbade LA. Green synthesis of chitosan-based iron@ silver nanocomposite as adsorbent for wastewater treatment. Water Resour. Indus. 2021;26:100158. [Google Scholar]
- 72.Jaworska M, Sakurai K, Gaudon P, Guibal E. Influence of chitosan characteristics on polymer properties. I: Crystallographic properties. Polymer Int. 2003;52(2):198–205. [Google Scholar]
- 73.Varma R, Vasudevan S. Extraction, characterization, and antimicrobial activity of chitosan from horse mussel Modiolus modiolus. Am. Chem. Soc. 2020;5(32):20224–22023. doi: 10.1021/acsomega.0c01903. [DOI] [PMC free article] [PubMed] [Google Scholar]
- 74.Tan W, et al. Design, synthesis of novel starch derivative bearing 1,2,3-triazolium and pyridinium and evaluation of its antifungal activity. Carbohyd. Polym. 2017;157:236–243. doi: 10.1016/j.carbpol.2016.09.093. [DOI] [PubMed] [Google Scholar]
- 75.Vasilev, A. etal. Thermal behavior of chitosan as a carbon material precursor under IR radiation. in IOPConferenceSeries:MaterialsScienceandEngineering. Vol. 693(1). 012002 (2019).
- 76.Olajire AA, Mohammed AA. Green synthesis of bimetallic Pd core Au shell nanoparticles for enhanced solid-phase photodegradation of low-density polyethylene film. J. Mol. Struct. 2020;1206:127724. [Google Scholar]
- 77.Uzun İ, Topal G. Synthesis and physicochemical characterization of chitin derivatives. J. Chem. 2013;2013(982638):1–8. [Google Scholar]
- 78.Rajam M, Pulavendran S, Rose C, Mandal AB. Chitosan nanoparticles as a dual growth factor delivery system for tissue engineering applications. Int. J. Pharm. 2011;410(1–2):145–215. doi: 10.1016/j.ijpharm.2011.02.065. [DOI] [PubMed] [Google Scholar]
- 79.Azeez AA, Rhee KY, Park SJ, Kim HJ, Jung DH. Application of cryomilling to enhance material properties of carbon nanotube reinforced chitosan nanocomposites. Compos. B Eng. 2013;50:127–134. [Google Scholar]
- 80.Liu Y, et al. Thermal degradation properties of biobased iron alginate film. J. Anal. Appl. Pyrol. 2016;119:87–96. [Google Scholar]
- 81.Praffulla SR, Bubbly SG. Synthesis and characterization of chitosan-CuO-MgO polymer nanocomposites. Am. Inst. Phys. Conf. Proc. 2018;1953(1):030168. [Google Scholar]
- 82.Kunasekaran V, Krishnamoorthy K. Compatibility studies of rasagiline mesylate with selected excipients for an effective solid lipid nanoparticles formulation. Int. J. Pharm. Pharm. Sci. 2015;7(1):73–80. [Google Scholar]
- 83.Kumirska J, et al. Application of spectroscopic methods for structural analysis of chitin and chitosan. Mar. Drugs. 2010;8(5):1567–1636. doi: 10.3390/md8051567. [DOI] [PMC free article] [PubMed] [Google Scholar]
- 84.Damiri F, Bachra Y, Bounacir C, Laaraibi A, Berrada M. Synthesis and characterization of lyophilized chitosan-based hydrogels cross-linked with benzaldehyde for controlled drug release. J. Chem. 2020;2020(8747639):1–10. [Google Scholar]
- 85.Anandalakshmi K, Venugobal J, Ramasamy V. Characterization of silver nanoparticles by green synthesis method using Pedalium murex leaf extract and their antibacterial activity. Appl. Nanosci. 2016;6(3):399–408. [Google Scholar]
- 86.Kheiri A, Jorf SM, Malihipour A, Saremi H, Nikkhah M. Application of chitosan and chitosan nanoparticles for the control of Fusarium head blight of wheat (Fusarium graminearum) in vitro and greenhouse. Int. J. Biol. Macromol. 2016;93:1261–1272. doi: 10.1016/j.ijbiomac.2016.09.072. [DOI] [PubMed] [Google Scholar]
- 87.Muller RH, Jacobs C, Kayser O. Nanosuspensions as particulate drug formulations in therapy rationale for development and what we can expect for the future. Adv. Drug Deliv. Rev. 2001;47:3–19. doi: 10.1016/s0169-409x(00)00118-6. [DOI] [PubMed] [Google Scholar]
- 88.Manikandan A, Sathiyabama M. Green synthesis of copper-chitosan nanoparticles and study of its antibacterial activity. J. Nanomed. Nanotechnol. 2015;6(1):1. [Google Scholar]
- 89.Khan MA, Zafaryab M, Mehdi SH, Quadri J, Rizvi MMA. Characterization and carboplatin loaded chitosan nanoparticles for the chemotherapy against breast cancer in vitro studies. Int. J. Biol. Macromol. 2017;97:115–122. doi: 10.1016/j.ijbiomac.2016.12.090. [DOI] [PubMed] [Google Scholar]
- 90.Raza ZA, Anwar F. Fabrication of chitosan nanoparticles and multi-response optimization in their application on cotton fabric by using a Taguchi approach. Nano-Struct. Nano-Obj. 2017;10:80–90. [Google Scholar]
- 91.Asal HA, Shoueir KR, El-Hagrasy MA, Toson EA. Controlled synthesis of in-situ gold nanoparticles onto chitosan functionalized PLGA nanoparticles for oral insulin delivery. Int. J. Biol. Macromol. 2022;209:2188–2196. doi: 10.1016/j.ijbiomac.2022.04.200. [DOI] [PubMed] [Google Scholar]
- 92.Qi L, Xu Z, Jiang X, Hu C, Zou X. Preparation and antibacterial activity of chitosan nanoparticles. Carbohyd. Res. 2004;339(16):2693–2700. doi: 10.1016/j.carres.2004.09.007. [DOI] [PubMed] [Google Scholar]
- 93.Vinodhini PA, et al. FTIR, XRD and DSC studies of nanochitosan, cellulose acetate and polyethylene glycol blend ultrafiltration membranes. Int. J. Biol. Macromol. 2017;104:1721–1729. doi: 10.1016/j.ijbiomac.2017.03.122. [DOI] [PubMed] [Google Scholar]
- 94.Feyzioglu GC, Tornuk F. Development of chitosan nanoparticles loaded with summer savory (Satureja hortensis L.) essential oil for antimicrobial and antioxidant delivery applications. Lebensmittel-Wissenschaft Technol. 2016;70:104–110. [Google Scholar]
- 95.Vijayalakshmi K, Devi BM, Sudha PN, Venkatesan J, Anil S. Synthesis, characterization and applications of nanochitosan/sodium alginate/microcrystalline cellulose film. J. Nanomed. Nanotechnol. 2016;7(419):2. [Google Scholar]
- 96.Coats AW, Redfern JP. Thermogravimetric analysis. A review. Analyst. 1963;88(1053):906–924. [Google Scholar]
- 97.Sivakami MS, et al. Preparation and characterization of nano chitosan for treatment wastewaters. Int. J. Biol. Macromol. 2013;57:204–212. doi: 10.1016/j.ijbiomac.2013.03.005. [DOI] [PubMed] [Google Scholar]
- 98.Morsy M, et al. Synthesis and characterization of freeze dryer chitosan nanoparticles as multi-functional eco-friendly finish for fabricating easy care and antibacterial cotton textiles. Egypt. J. Chem. 2019;62(7):1277–1293. [Google Scholar]
- 99.Peng J, et al. Antibacterial mechanism of peptide Cec4 against Acinetobacter baumannii. Infect. Drug Resist. 2019;12:2417. doi: 10.2147/IDR.S214057. [DOI] [PMC free article] [PubMed] [Google Scholar]
- 100.Xing K, et al. Effect of oleoyl-chitosan nanoparticles as a novel antibacterial dispersion system on viability, membrane permeability and cell morphology of Escherichia coli and Staphylococcus aureus. Carbohyd. Polym. 2009;76(1):17–22. [Google Scholar]
- 101.Ganan M, Carrascosa AV, Martinez-Rodriguez AJ. Antimicrobial activity of chitosan against Campylobacter spp. and other microorganisms and its mechanism of action. J. Food Protect. 2009;72(8):1735–1738. doi: 10.4315/0362-028x-72.8.1735. [DOI] [PubMed] [Google Scholar]
- 102.Xing Y, et al. Comparison of antimicrobial activity of chitosan nanoparticles against bacteria and fungi. Coatings. 2021;11(7):769. [Google Scholar]
- 103.Avadi MR, et al. Diethylmethyl chitosan as an antimicrobial agent: Synthesis, characterization and antibacterial effects. Eur. Polymer J. 2004;40(7):1355–1361. [Google Scholar]
- 104.Wu T, et al. Integration of lysozyme into chitosan nanoparticles for improving antibacterial activity. Carbohyd. Polym. 2017;155:192–200. doi: 10.1016/j.carbpol.2016.08.076. [DOI] [PubMed] [Google Scholar]
- 105.Chen CZ, Cooper SL. Interactions between dendrimer biocides and bacterial membranes. Biomaterials. 2002;23(16):3359–3368. doi: 10.1016/s0142-9612(02)00036-4. [DOI] [PubMed] [Google Scholar]
- 106.Chandrasekaran M, Kim KD, Chun SC. Antibacterial activity of chitosan nanoparticles: A review. Processes. 2020;8(9):1173. [Google Scholar]
- 107.Quan Z, et al. Synthesis and antimicrobial activities of chitosan/polypropylene carbonate-based nanoparticles. R. Soc. Chem. Adv. 2021;11(17):10121–10129. doi: 10.1039/d0ra09257f. [DOI] [PMC free article] [PubMed] [Google Scholar]
- 108.Yu Z, et al. Reactive oxygen species-related nanoparticle toxicity in the biomedical field. Nanoscale Res. Lett. 2020;15(1):1–14. doi: 10.1186/s11671-020-03344-7. [DOI] [PMC free article] [PubMed] [Google Scholar]
- 109.Dizaj SM, Lotfipour F, Barzegar-Jalali M, Zarrintan MH, Adibkia K. Antimicrobial activity of the metals and metal oxide nanoparticles. Mater. Sci. Eng. C. 2014;44:278–284. doi: 10.1016/j.msec.2014.08.031. [DOI] [PubMed] [Google Scholar]
Associated Data
This section collects any data citations, data availability statements, or supplementary materials included in this article.
Supplementary Materials
Data Availability Statement
All data generated or analyzed during this study are included in this article.